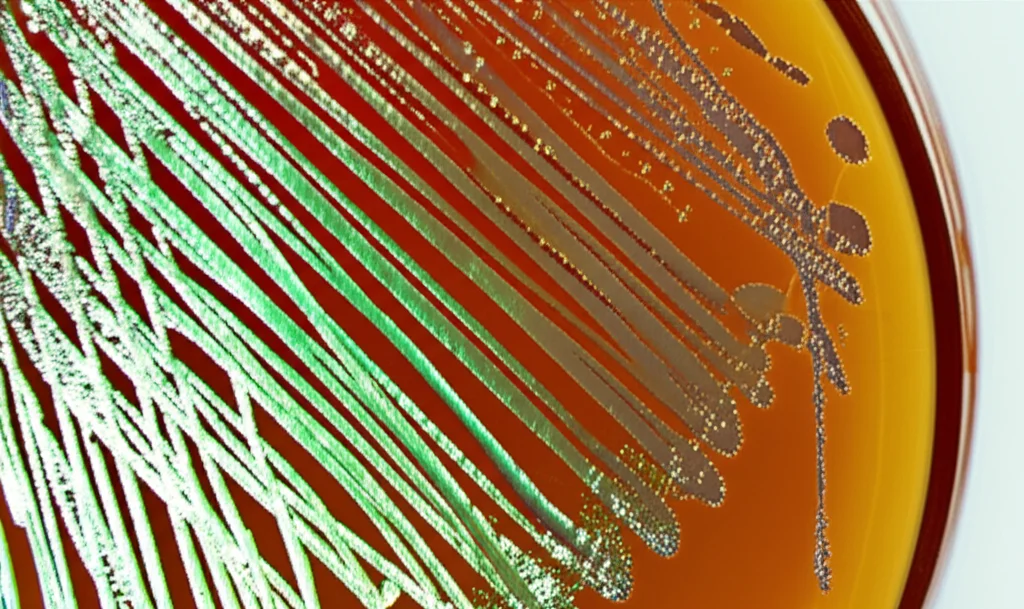
Microfotografia di colonie di Pasteurella multocida su piastra di agar sangue, lente macro 90mm, alta definizione, illuminazione controllata da laboratorio, focus preciso sulle colonie iridescenti.

Pasteurella multocida: Svelando i Segreti del Sierogruppo B e la Sfida della Protezione Incrociata
Ciao a tutti! Oggi voglio portarvi con me in un viaggio affascinante nel mondo della microbiologia, alla scoperta di un batterio tanto comune quanto potenzialmente pericoloso: Pasteurella multocida. Immaginatelo come un coinquilino silenzioso che vive nelle vie respiratorie di molti animali sani. La maggior parte delle volte se ne sta buono, ma attenzione! Questo coccobacillo Gram-negativo ha un arsenale nascosto di “armi” – i cosiddetti fattori di virulenza – che possono trasformarlo in un agente patogeno temibile, causando gravi malattie respiratorie soprattutto nel bestiame, con perdite economiche non indifferenti.
Nel nostro studio, ci siamo tuffati proprio nell’analisi di questo microrganismo, concentrandoci in particolare sul sierogruppo B. Volevamo capire meglio quali fossero i suoi geni di virulenza e, soprattutto, testare l’efficacia di un vaccino inattivato derivato da questo sierogruppo, vedendo se potesse offrire una protezione “incrociata”, cioè anche contro altri sierogruppi, come il tipo E. Pronti a scoprire cosa abbiamo trovato?
L’Indagine Ha Inizio: Caccia a Pasteurella multocida
La prima fase del nostro lavoro è stata una vera e propria “caccia al batterio”. Abbiamo raccolto ben 250 campioni da animali che mostravano sintomi respiratori: bovini, ovini, caprini e persino qualche uccellino domestico. Si trattava sia di tessuti polmonari prelevati da animali deceduti di recente, sia di tamponi nasali.
Una volta in laboratorio, abbiamo messo questi campioni in coltura su un terreno speciale, agar sangue al 5%, l’ambiente ideale per far crescere la nostra Pasteurella. Dopo 24 ore a 37°C, abbiamo osservato le piastre: cercavamo colonie con caratteristiche specifiche (piccole, non emolitiche, a volte con una particolare iridescenza). Abbiamo ottenuto 27 isolati sospetti.
Ma come essere sicuri che si trattasse proprio di P. multocida? Qui entra in gioco la biologia molecolare! Abbiamo utilizzato la PCR (Reazione a Catena della Polimerasi), una tecnica potentissima che permette di amplificare specifiche sequenze di DNA. Puntando al gene kmt1, un marcatore specifico per P. multocida, abbiamo confermato l’identità di 21 isolati (l’8.4% del totale). La maggior parte proveniva dai bovini (12), seguiti da ovini (5), capre (3) e un uccellino (1).
Sotto la Lente: I Geni della Virulenza
Identificato il “colpevole”, era ora di capire quanto fosse “armato”. Abbiamo quindi analizzato i nostri isolati per la presenza di 19 geni associati alla virulenza. Questi geni sono come i progetti per costruire le armi del batterio: proteine della membrana esterna, fimbrie (strutture simili a peli per aderire alle cellule ospiti), antigeni somatici, sistemi per “rubare” il ferro all’ospite (fondamentale per la sopravvivenza batterica) e tossine.
Prima di tutto, abbiamo cercato i geni specifici per i sierogruppi B (capB o bcbD) ed E (capE o ecbJ), trovando due isolati positivi per il tipo B (da bovini) e uno per il tipo E (da ovini). Poi, abbiamo passato al setaccio questi tre isolati per gli altri 19 geni di virulenza.
I risultati sono stati interessanti:
- Alcuni geni (plpB, tadD, gatG, hgbA) erano presenti sia negli isolati di tipo B che in quello di tipo E. Questi potrebbero rappresentare un “arsenale di base” condiviso.
- Altri geni, invece, erano completamente assenti in tutti e tre gli isolati testati (ompA, toxA, pcgD, latB, nctB, ppgB, natG, hgbB, exbB). Questo suggerisce che, almeno nei nostri campioni, questi specifici fattori di virulenza non giocassero un ruolo primario.
- I due isolati di sierogruppo B erano molto simili nel loro profilo di geni di virulenza (avevano 8 dei 19 geni cercati), mentre l’isolato di tipo E ne possedeva 7, con qualche differenza rispetto ai B.
Questo screening ci ha dato un’idea più chiara delle potenzialità patogene dei ceppi circolanti nella nostra area di studio, evidenziando che anche con un numero apparentemente limitato di fattori di virulenza noti, questi batteri possono comunque causare malattia.
Costruire lo Scudo: Il Vaccino Inattivato
Il passo successivo era la sfida più grande: potevamo usare uno di questi ceppi, specificamente il sierogruppo B, per creare un vaccino efficace? E questo vaccino sarebbe stato in grado di proteggere non solo da un’infezione dello stesso tipo (B), ma anche da un tipo diverso (E)? Questa è la cosiddetta protezione incrociata, il Sacro Graal della vaccinologia!
Abbiamo preparato un vaccino “inattivato”. In pratica, abbiamo coltivato grandi quantità del nostro isolato di P. multocida sierogruppo B, lo abbiamo “ucciso” con formaldeide (in modo che non potesse più causare malattia) e lo abbiamo purificato. Per potenziare la risposta immunitaria, abbiamo aggiunto un adiuvante, il Montanide ISA 206 VG, una sostanza che stimola il sistema immunitario a reagire meglio al vaccino. Ovviamente, abbiamo testato rigorosamente la sterilità e la sicurezza del vaccino su un piccolo numero di topi, come da protocolli etici.
Poi è iniziato l’esperimento principale su 100 topoline Swiss albino. Le abbiamo divise in gruppi e abbiamo testato due diverse vie di somministrazione del vaccino:
- Sottocutanea (SC): l’iniezione sotto la pelle.
- Intramuscolare (IM): l’iniezione nel muscolo.
Abbiamo somministrato una prima dose e poi una dose di richiamo (booster) dopo alcune settimane. Abbiamo prelevato campioni di sangue a 21 e 35 giorni dalla prima vaccinazione per misurare il livello di anticorpi IgG specifici contro P. multocida B, usando una tecnica chiamata ELISA.
Il Momento della Verità: Risposta Immunitaria e Protezione Incrociata
I risultati dell’analisi degli anticorpi sono stati molto chiari. Sia la via sottocutanea che quella intramuscolare hanno indotto una buona produzione di anticorpi contro il sierogruppo B.
- A 21 giorni, la via sottocutanea ha mostrato livelli di anticorpi leggermente, ma significativamente, più alti.
- A 35 giorni (dopo il booster), entrambe le vie hanno mostrato un aumento degli anticorpi, ma la via intramuscolare ha avuto un incremento più rapido e marcato.
L’analisi statistica ha confermato che c’erano differenze significative sia tra i diversi momenti del prelievo (21 vs 35 giorni, p < 0.001) sia tra le due vie di somministrazione (SC vs IM, p < 0.001). Quindi, il vaccino funzionava nell'attivare il sistema immunitario dei topi contro il sierogruppo B.
Ma la domanda cruciale rimaneva: questa immunità si estendeva anche al sierogruppo E? Per scoprirlo, abbiamo sottoposto i topi vaccinati (e un gruppo di controllo non vaccinato) a una prova del fuoco: l'infezione sperimentale (challenge) con dosi letali (LD50) di P. multocida viva, sia del sierogruppo B che del sierogruppo E.
I risultati sono stati netti e, in parte, deludenti:
- Tutti i topi vaccinati con il siero B e poi infettati con il siero B sono sopravvissuti (100% di protezione). Ottimo!
- Quasi tutti i topi vaccinati con il siero B e poi infettati con il siero E sono morti entro 28 ore, con un’unica eccezione nel gruppo IM. Disastro!
Questo significa che il nostro vaccino a base di sierogruppo B, pur essendo immunogenico e protettivo contro se stesso, non è riuscito a fornire una protezione incrociata efficace contro il ceppo di sierogruppo E che abbiamo testato.

Confronti e Prospettive: Cosa Ci Dice la Scienza?
Questi risultati ci portano a riflettere. Da un lato, confermiamo che un vaccino inattivato contro P. multocida può indurre una forte risposta immunitaria e protezione omologa (contro lo stesso sierotipo), in linea con alcuni studi precedenti (come quello di Akhtar et al., 2016) ma in contrasto con altri (Dowling et al., 2004, che non trovarono protezione nei vitelli). La scelta dell’adiuvante (il nostro Montanide ISA 206) e la via di somministrazione giocano chiaramente un ruolo importante, come evidenziato anche da altri ricercatori (Ashraf et al., 2014).
Dall’altro lato, la mancanza di protezione incrociata è un problema noto e complesso. Anche se i nostri ceppi B ed E condividevano alcuni geni di virulenza (come plpB, tadD, gatG, hgbA), evidentemente non erano sufficienti a generare un’immunità protettiva trasversale. Questo contrasta con alcune ricerche, come quelle di Rimler (1996), che suggerivano possibili relazioni immunologiche e protezione incrociata tra diversi sierotipi, forse mediate da proteine comuni come le porine. Tuttavia, i nostri dati sono più in linea con l’idea generale che l’immunità contro P. multocida sia spesso sierogruppo-specifica, legata principalmente agli antigeni capsulari.
È interessante notare che nel nostro studio non abbiamo rilevato geni importanti come toxA (che codifica per la tossina dermonecrotica PMT) o alcuni geni per l’acquisizione del ferro (hgbB, exbB), che altri studi hanno trovato prevalenti (Vu-Khac et al., 2020; Sahoo et al., 2023). Questo sottolinea la grande variabilità genetica di P. multocida e come i profili di virulenza possano cambiare a seconda della regione geografica, della specie ospite e del tipo di malattia.
Conclusioni (Provvisorie) di un Viaggio Scientifico
Cosa portiamo a casa da questo studio? Abbiamo visto che Pasteurella multocida sierogruppo B, anche se nel nostro caso sembrava possedere un numero relativamente basso di fattori di virulenza noti, è perfettamente in grado di stimolare una forte risposta immunitaria nei topi quando usata in un vaccino inattivato con un buon adiuvante. La via sottocutanea sembra dare una spinta iniziale migliore, mentre quella intramuscolare risponde bene al richiamo.
Tuttavia, il grande limite è la specificità: la protezione è rimasta confinata al sierogruppo B, senza estendersi al tipo E. Questo ci ricorda che la lotta contro le infezioni da P. multocida nel bestiame richiede probabilmente strategie vaccinali più mirate o lo sviluppo di vaccini di nuova generazione (magari basati su proteine conservate tra diversi sierotipi o tecniche ricombinanti avanzate, come suggerito da studi recenti come Fegan et al., 2024) che possano offrire una protezione più ampia.
Certo, il nostro studio ha dei limiti: abbiamo analizzato campioni da una regione specifica e solo due sierogruppi, e i topi sono un modello animale, non la copia esatta di bovini o ovini. Ma ogni tassello di conoscenza è fondamentale per comporre il complesso puzzle di Pasteurella multocida e per sviluppare strumenti sempre più efficaci per proteggere la salute animale e, indirettamente, la nostra economia. La ricerca continua!

Fonte: Springer
